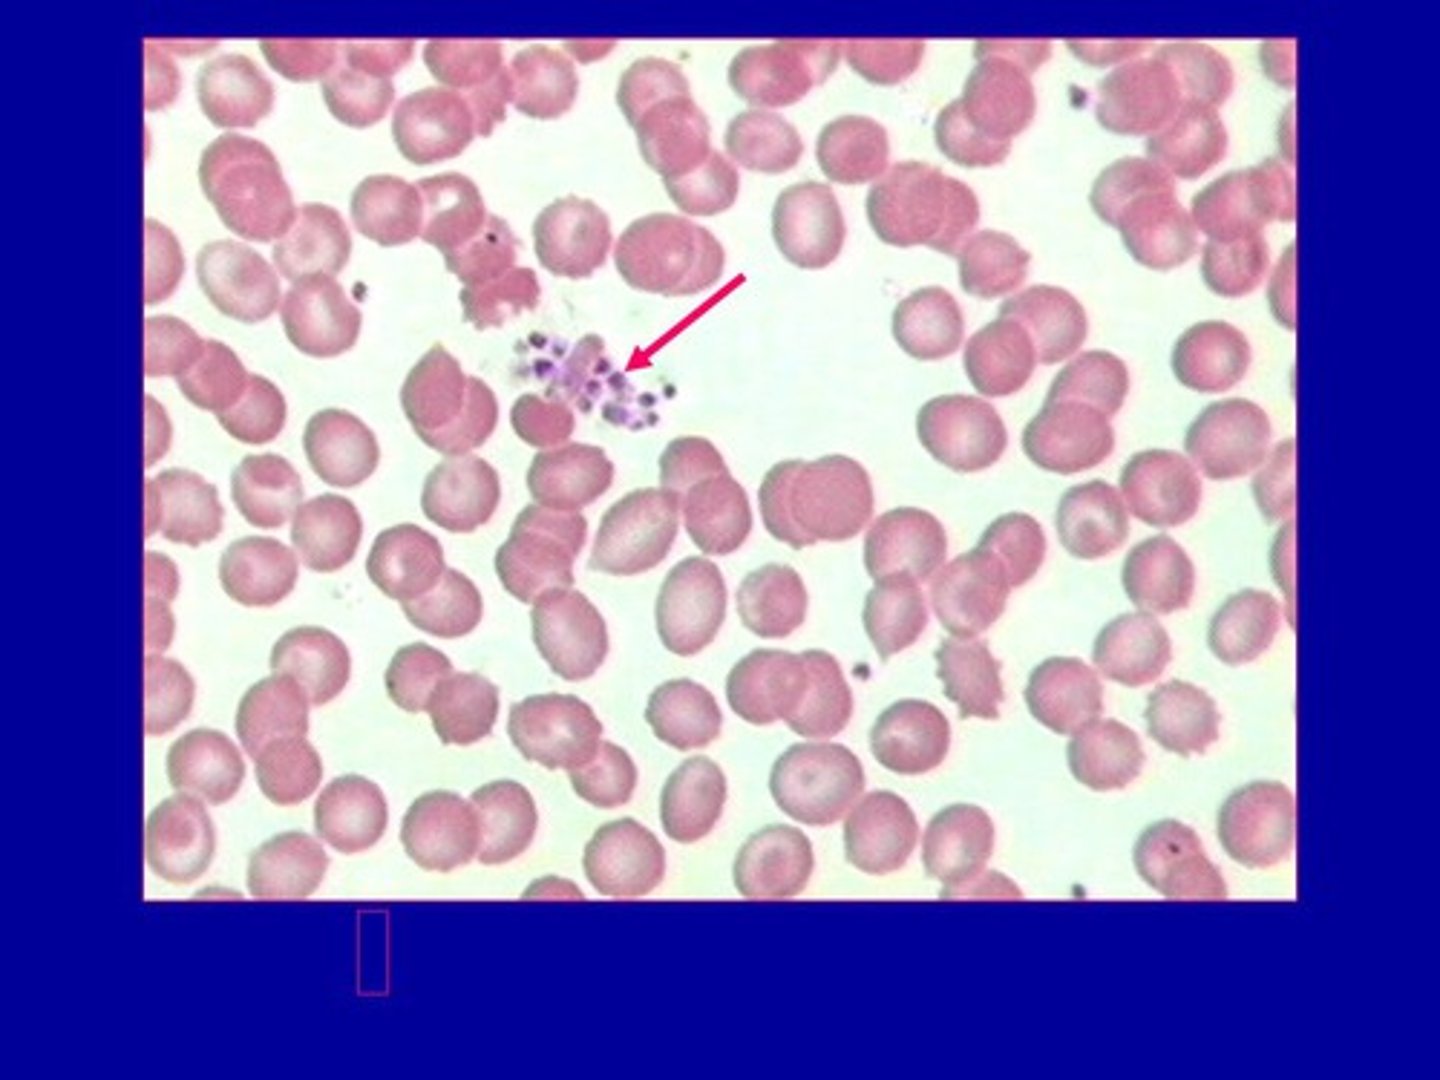
<p>- function: hemostasis (stopping bleeding) and wound healing</p><p>- 150,000–400,000 in 1 mm³</p><p>- They are NOT cells but cell fragments </p><p>- elevated platelet count = thrombocytosis</p><p>- low platelet count = thrombocytopenia</p>

A&P II GTC - Exam 2 first half: Blood and Heart
1/266
There's no tags or description
Looks like no tags are added yet.
Name | Mastery | Learn | Test | Matching | Spaced | Call with Kai |
|---|
No analytics yet
Send a link to your students to track their progress
267 Terms
Blood General Characteristics
- normal pH range: 7.35-7.45 (slightly basic)
- total liters of blood: 4-6 liters (approx: 1.2 - 1.6 gallons in adults)
- a type of connective tissue

Is plasma extracellular or intracellular fluid
extracellular
Whole Blood has two components:
blood plasma (55%) and formed elements (45%)
plasma components
1. water
2. solutes and plasma proteins: gases, hormones, enzymes, waste products, ions, etc.
plasma proteins
i. albumin: plays a role in maintaining osmotic pressure
ii. fibrinogen: blood clotting
iii. other clotting factors
iv. globulins such as antibodies and transport proteins

What is osmotic pressure? When there is a lot of albumin in the blood, is osmotic pressure high or low?
the pressure exerted by solutes that draws water across a semipermeable membrane; high

formed elements (cells and cell fragments)
- red blood cells (RBC) = erythrocytes: carry oxygen in the bloodstream
- white blood cells (WBC) = leukocytes: immune functions
- platelets = thrombocytes: clotting function
the most numerous formed element is what? The ratio of RBCs to WBCs and plasma is approximately?
Red blood cells, 1000 (RBC) to 1 (WBC), 10 (RBC) to 1 (plasma)
Hematocrit (Hct)
% of red blood cells in whole blood (normal is 38–55% – varies with age and sex)
- no units, only percentage

When whole blood is centrifuged, it separates into cells at the bottom of the tube and __________ at the top. The ____________ and ___________create a "buffy coat" in between the plasma and red blood cells.
plasma; white blood cells; platelets
Hematopoiesis
whole blood formation (RBCs, WBCs and platelets)
erythropoiesis
formation of red blood cells
leukopoiesis
formation of white blood cells
All blood cells are made where? Are they made in the same place for adults and fetus?
adult: red bone marrow
Fetus: liver, spleen, and thymus

Where is red bone marrow located?
in the spongy bone of flat bones (skull, ribs, sternum, pelvis) and the proximal epiphyses of long bones

hematopoietic stem
cell in the bone marrow that gives rise to all types of blood cells. Depending on which external factors act on it, the hematopoietic stem cell can become any cells (RBC, WBC, platelets)
- They undergo mitosis

Why is the hematopoietic stem cell important in bone marrow transplants?
because transplanted stem cells can repopulate the bone marrow and produce all types of blood cells
How does the hematopoietic stem cell "know" which type of cell to become?
by responding to specific growth factors and hormones
growth factors acting on bone marrow cells (affect growth of certain cells)
1. erythropoietin: hormone made by kidney when oxygen is low. Erythropoietin increases erythropoiesis in the bone marrow
2. colony stimulating factors: primarily increase growth of white blood cells
Red Blood Cell (RBC) size:
about 7-8 micrometers in diameter
How long do RBCs live?
About 120 days
In which organ(s) are they destroyed?
liver and spleen
- Kupffer cells in the liver sinusoid destroys old red blood cells
reticulocyte
immature erythrocyte (RBC) that loses its nucleus to become a red blood cell.
When the rate of erythropoiesis is high a(n) ____________ (increased/decreased) number of reticulocytes are found in the blood.
Increased
Which vitamins are important for erythropoiesis?
vitamin B12 and folic acid
What happens to hemoglobin when it is broken down (by the liver and spleen)?
i. iron: recycled and reused or stored
ii. heme: converted to bilirubin and excreted in bile
iii. globin: broken down into amino acids
cellular characteristics of RBCs
No nucleus or mitochondria, produce ATP by anaerobic glycolysis
What is polycythemia?
an abnormally high number of red blood cells
What is anemia? What symptoms or signs are present in anemia?
a condition characterized by a low number/decrease of RBCs or low hemoglobin (oxygen-carrying capacity of blood)
symptoms: fatigue, weakness, pale skin, shortness of breath
What is the cause of each of the following anemias caused by low RBC number, faulty RBCs?
hemorrhagic anemia, hemolytic anemia, aplastic anemia, pernicious anemia
hemorrhagic anemia: blood loss
hemolytic anemia: premature destruction of RBCs
aplastic anemia: failure of red bone marrow to produce blood cells
pernicious anemia: vitamin B12 deficiency due to lack of intrinsic factor
What is the cause of each of the following anemias caused by low hemoglobin, faulty hemoglobin?
iron deficiency anemia, sickle-cell anemia
iron deficiency anemia: lack of iron
sickle-cell anemia: genetic abnormal hemoglobin causing sickle-shaped RBCs
How prevalent is hemoglobin in the red blood cell?
it makes up about 95% of the RBC interior
What is oxyhemoglobin? What color is oxyhemoglobin?
hemoglobin bound to oxygen; bright red
What element binds to oxygen in hemoglobin?
iron
How many oxygen molecules can bind to one hemoglobin molecule?
4

What is normal hemoglobin for women and men?
Women: 12–16 g/dL
Men: 14–18 g/dL
- measured in grams per deciliter (g/dL)
What is carbaminohemoglobin (also carbaminoglobin, carbohemoglobin)?
hemoglobin bound to carbon dioxide
What determines blood type?
Glycoproteins and glycolipids (proteins with sugars or fats attached) are found on the surface of red blood cells and determine blood type. These structures can act as antigens
agglutinogens
when they bind with antibodies in an immune response, they cause the red blood cells to agglutinate
if blood is received from someone else with different antigens (in this case different glycoproteins or glycolipids on the surface of red blood cells), the immune system will __________those cells. It does so through plasma proteins called ___________.
Attack; Antibodies.
why is it important only to receive blood from someone with a compatible blood type?
antibodies will attach to those foreign antigens causing the red blood cells to agglutinate. The clumps caused by agglutination would stop the circulation in small blood vessels, a very dangerous condition
two RBC antigens that will be emphasized in this course:
the ABO antigens and the Rh (also called D) antigen.
The Rh factor (D antigen) makes the blood type.....
positive or negative; If the D antigen is present on the RBC, the person is positive. If the D antigen is not present, the person is negative
two surface glycolipids that play a role in determining blood type.
A and B
There are four possibilities concerning A and B glycolipids on a red blood cell:
- Only glycolipid (antigen) A is present on the RBC = blood group A.
- Only glycolipid (antigen) B is present on the RBC = blood group B.
- Both glycolipids (antigens) A and B are present on the RBC = blood group AB
- Neither A nor B glycolipids (antigens) are present = blood group O

Each blood type has antibodies (in the plasma) ________ (against/with) the A or B antigens it does not possess.
Against (opposite)
Blood group A has which antigens and antibodies?
A antigen and B antibodies
Blood groups A, B, O, or AB are additionally designated as positive or negative? T or F
True
If the A and D antigens are present, the person would have what blood type?
A+ blood
If the A and B antigens are present, but the D is not, the person would have?
AB- blood
In the ABO/Rh system, there are 8 blood types. List them and the antigens on them?
Blood type | antigens on the RBC
A + | A, D
A- | A
B + | B, D
B- | B
O + | D
O- | none
AB + | A, B, D
AB- | A, B
Antibodies against the antigens of the ABO system are essentially present from birth. T or F
True
Antibodies against the antigens of the Rh factor (D antigen) are essentially present from birth. T or F
False; the person who is Rh negative (no D antigen on the RBC) does not have antibodies against the D antigen until that person is exposed to the D antigen through exposure to Rh positive blood.
theoretically an Rh- person could receive Rh+ blood one time. T or F
True; It is not until the Rh- person makes antibodies (after one exposure) that the person is in danger of a transfusion reaction
- Rh+ blood is not given to Rh- patients in a clinical setting
A person with A antibodies in the plasma could not receive red blood cells with the A antigen, because ______________ would occur
agglutination (clumping)

Who can donate to whom?
Always examine the donor's RBCs (antigens present) and the recipient's antibodies. If they react, the blood types are not compatible
Can a person with A+ blood receive blood from AB+? Why or why not?
No, because AB+ donor RBCs have B antigens that would react with the recipient's B antibodies.
Can a person with B- blood receive blood from O-? Why or why not?
Yes, because O- RBCs have no antigens to react with the recipient's antibodies.
A person with O- blood can donate to any blood type. T or F
True; because O- has no antigens.= universal donor
A person with AB+ blood can receive from any blood type. T or F
True; because AB+ has no antibodies. = universal recipient
Can AB+ blood donate to O+? Why or why not?
No, because O+ has A and B antibodies that would react with AB antigens
Can B+ blood donate to B-? Why or why not?
No, because the D antigen would react with D antibodies in the Rh- recipient.
Rh- women during pregnancy
- Most people are Rh+. That means that Rh- mothers can become pregnant with Rh+ children.
- D antibodies can cross the placenta from mother to baby
- patients with Rh- blood are not given Rh+ blood. If the patient is a young female, she would develop D antibodies and be unable to carry an Rh+ child.
- Mothers who are Rh- are given Rhogam before and after delivery. Rhogam contains D antibodies.
A person who is A- and is exposed to A+ blood will now have both B and D antibodies. what blood type is that person now?
A person's blood type never changes. the person is still A-
Leukocytes (WBCs) general characteristics and numbers
- Has a nuclei
- no hemoglobin
- WBC are larger then RBC
- 5,000-10,000mm³

What is the significance of histocompatibility proteins on the surface of WBCs? What is the major histocompatibility complex?
they help the immune system distinguish self from non-self; the major histocompatibility complex is a group of proteins that identify cells as belonging to the body
What is the clinical term for too many white blood cells? What is the clinical term for too few white blood cells?
Too many WBC - leukocytosis
Too few WBC - leukopenia
How do agranular and granular leukocytes differ? Where are each made?
granular leukocytes have visible cytoplasmic granules; agranular do not

Where are agranular lymphocytes made?
red bone marrow and lymphatic tissues
Where are granular leukocytes made?
red bone marrow
What is the general function of WBCs in the body?
defense and immunity
Define diapedesis (also called emigration). Which blood cells are capable of diapedesis?
movement of white blood cells out of blood vessels into tissues; all leukocytes are capable and RBCS cannot

What is chemotaxis?
movement of white blood cells toward a chemical signal (like an injury)
What is phagocytosis?
engulfment and digestion of pathogens or debris by a cell
Neutrophils
- 50–70% in WBC differential
- major function of neutrophils: phagocytosis of bacteria
- purposes of defensins, lysozyme, and oxidants in the granules of neutrophils is to destroy bacteria and other pathogens

What is the difference between a band and a PMN (polymorphonuclear leukocyte or "seg")?
a band has an immature, unsegmented nucleus; a PMN has a segmented nucleus
If a patient has too many neutrophils, what may that indicate?
acute bacterial infection
Eosinophils
- 2–4% WBC in differential
- The granules in eosinophils have chemicals that attack parasitic worms
- play a role in allergic responses such as asthma
- important cells in regulating the immune response.

Basophils
- 0.5–1% WBC in differential
- The granules of basophils contain histamine, heparin and serotonin
i. histamine: vasodilation and increased capillary permeability
ii. heparin: prevents clotting
iii. serotonin: vasoconstriction

Explain the significance of basophils in anaphylactic shock.
massive histamine release causes extreme vasodilation and drop in blood pressure
Lymphocytes
- 20–40% WBC in differential.
- three major types of lymphocytes
i. B-lymphocyte - produce antibodies
ii. T-lymphocyte cell - mediated immunity
iii. NK cell - destroy virus-infected and cancer cells

What might an elevated number of lymphocytes indicate?
viral infection
monocyte
- 2–8% WBC in differential
- Function: fighting infection via phagocytosis, antigen presentation, and cytokine production
- Monocytes leave the blood and become macrophages
Name places tissue macrophages are located:
a. liver (Kupffer cells)
b. lungs (alveolar macrophages)
c. lymph nodes and spleen
white blood cell differential: a count of 100 WBCs
The % of each of the five types of WBCs is determined and compared with normal ranges. An elevation (or reduction) of one particular type of blood cell can support a diagnosis.
Thrombocytes (Platelets): general characteristics
- function: hemostasis (stopping bleeding) and wound healing
- 150,000–400,000 in 1 mm³
- They are NOT cells but cell fragments
- elevated platelet count = thrombocytosis
- low platelet count = thrombocytopenia
Are platelets derived from the same hematopoietic stem cell as red blood cells and white blood cells?
Yes
What is a megakaryocyte?
a large bone marrow cell responsible for the production of blood thrombocytes (platelets)

Important substances found in platelets (5):
1. contractile proteins (actin and myosin)
2. clotting factors
3. ADP
4. serotonin
5. thromboxane A2 (helps platelets stick together and aggregate.)
Why might a baby aspirin be helpful during a heart attack?
it inhibits platelet aggregation and clot formation
3 major steps involved in hemostasis
1. Vascular spasm
2. Platelet plug
3. coagulation

vascular spasm (step 1 of hemostasis)
Damage to the wall of a vessel causes contraction of the smooth muscle. Vasoconstriction helps to limit blood loss

platelet plug (step 2 of hemostasis)
When platelets come in contact with the damaged lining of blood vessel (endothelium), the platelets stick to the exposed collagen.

What do platelets do?
- They stick.
- They break apart releasing their chemicals (ADP, thromboxane).
- This makes more platelets stick and break apart.
- The end result is a platelet plug.
Explain why the formation of a platelet plug is a positive feedback mechanism
activated platelets release chemicals that activate more platelets
What is the significance of prostacyclin?
it prevents platelet aggregation in intact vessels
coagulation (step 3 of hemostasis)
Permanent plug (clot) is actually insoluble fibrin

What does coagulation require:
- clotting factors made in the liver (FII, FVII, FIX, FX made from vitamin K)
- calcium: needed for many steps
- platelet factors
- tissue factor from damaged cells
Clotting process:
a. Damaged cells release chemicals that activate clotting factors. In a cascade of reactions, one clotting factor activates the next until the prothrombin activator complex (or prothrombinase) is formed.
b. Prothrombinase catalyzes the following reaction:
prothrombin (plasma protein) → thrombin (another enzyme)
c. Thrombin catalyzes the following reaction:
fibrinogen (plasma protein) → fibrin (insoluble protein)
- The clot is insoluble fibrin.
d. retraction (also called syneresis)
Platelets "pull" fibrin taut. Serum escapes.

There are two pathways that lead to the formation of prothrombin activator complex:
i. intrinsic pathway: due to damage to blood vessel (endothelium)
ii. extrinsic pathway (faster): due to additional tissue damage